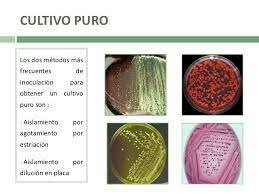
TÉCNICAS DE MICROORGANISMOS EN CULTIVOS PUROS

Historia de la fito patología y Generalidades de la micro biología.Por: Leidy Carolina Herrera Gutiérrez
-
 Registró las incidencias periódicas de las royas
Registró las incidencias periódicas de las royas
del trigo, observando que en unos años era mayor que en otros y
relacionó esto con las condiciones ambientales. -
 Publica el libro “Historia de las plantas” en el
Publica el libro “Historia de las plantas” en el
cual hace referencia a las enfermedades, señalando el hecho que las
plantas cultivadas eran más susceptibles a éstas que los silvestres.
También distingue las enfermedades parasitarias de las fisiológicas. -
 Consideraba entre los principales causantes detizón o quemados de los árboles “La savia superflua con inflamación dela misma”.
Consideraba entre los principales causantes detizón o quemados de los árboles “La savia superflua con inflamación dela misma”. -
 Describe hongos de los géneros Aspergillus, Botritis y Puccinia
Describe hongos de los géneros Aspergillus, Botritis y Puccinia -
 Estudia algunas enfermedades entre royas y carbones.
Estudia algunas enfermedades entre royas y carbones. -
 Señalan que las royas u los carbones del trigo consistían en la vegetación del hongo que emergía debajo de la epidermis de la planta.
Señalan que las royas u los carbones del trigo consistían en la vegetación del hongo que emergía debajo de la epidermis de la planta. -
 Estudio de la anatomía de las plantas, hongos, bacterias y microorganismos.
Estudio de la anatomía de las plantas, hongos, bacterias y microorganismos. -
 Prevost apaga que el carbón que cubre al trigo es ocasionado por un hongo y rechazo la generación espontanea.
Prevost apaga que el carbón que cubre al trigo es ocasionado por un hongo y rechazo la generación espontanea. -
 Hicieron estudios sobre la biología de hongos (Ersifaceas, uredinales, ustilaginales y algunos Pirenimicetos), donde revelan la naturaleza parasitaria de las royas y carbones y descubre el polimorfismo de las royas. Con estos descubrimientos desaparece la escuela autogenista.
Hicieron estudios sobre la biología de hongos (Ersifaceas, uredinales, ustilaginales y algunos Pirenimicetos), donde revelan la naturaleza parasitaria de las royas y carbones y descubre el polimorfismo de las royas. Con estos descubrimientos desaparece la escuela autogenista. -
 La devastadora destrucción de cultivos en Irlanda ocasionados por Phytopthora Infestans debido a esto muchas personas fallecieron de hambre (el agente causal no fue descubierto hasta 1861).
La devastadora destrucción de cultivos en Irlanda ocasionados por Phytopthora Infestans debido a esto muchas personas fallecieron de hambre (el agente causal no fue descubierto hasta 1861). -
 Demostración experimentalmente PHYTOPTHORA INFESTANS causante de la enfermedad en Irlanda.
Demostración experimentalmente PHYTOPTHORA INFESTANS causante de la enfermedad en Irlanda. -
Brefeld contribuyo mucho a la fitopatologia ya que desarrollo tecnicas de cultivos de microorganismos en cultivos puros, tecnicas perfeccionadas por Koch, Petri y otros.
Brefeld contribuyo mucho a la fitopatologia ya que desarrollo tecnicas de cultivos de microorganismos en cultivos puros, tecnicas perfeccionadas por Koch, Petri y otros. -
 Etiologia de la tuberculosis por medio de un experimento de la enfermedad infecciosa y bacteriana.
Etiologia de la tuberculosis por medio de un experimento de la enfermedad infecciosa y bacteriana. -
 Comprobó el mosaico del tabaco, no transmitiéndose en el jugo de plantas enfermas sino una bacteria.
Comprobó el mosaico del tabaco, no transmitiéndose en el jugo de plantas enfermas sino una bacteria. -
 Conduce investigaciones para controlar
Conduce investigaciones para controlar
el hongo Phytohpthora infestans. También estudió el efecto de la
temperatura en el desarrollo del causante de la enfermedad. -
 Fue el primero en demostrar la entrad del micelio
Fue el primero en demostrar la entrad del micelio
del hongo en las planticas de trigo y verificar su desarrollo en el
huesped hasta la formación de las esporas en el grano. -
 En este año se hizo el primer cultivo de tejidos vegetales.
En este año se hizo el primer cultivo de tejidos vegetales. -
 Stewart aplico la embriogenesis y acabarán que podrán incluirse cultivos de zanahoria por suspensión para formar embriones.
Stewart aplico la embriogenesis y acabarán que podrán incluirse cultivos de zanahoria por suspensión para formar embriones. -
 revelaron aspectos regulatorios que son clave
revelaron aspectos regulatorios que son clave
para comprender el ciclo de división celular. En este contexto,
resultó sorprendente comprobar que las conclusiones de sus
estudios, realizados fundamentalmente utilizando la levadura
Schizosaccharomyces pombe, tenían validez para células de
otras especies superiores, incluyendo al hombre. -
 Esta situación recuerda las palabras de
Esta situación recuerda las palabras de
Pasteur cuando decía: “señores, son los microbios los que
tendrán la última palabra”. Parece, en efecto, que puede ser
así, pues los microorganismos nos precedieron
evolutivamente y, con toda seguridad, permanecerán sobre la
Tierra cuando el hombre desaparezca como especie.
Looking for a timeline maker?
Create timelines for projects, roadmaps, history, lessons, legal cases, and stories with Timetoast. Timetoast is a timeline maker for work, school, research, and stories.